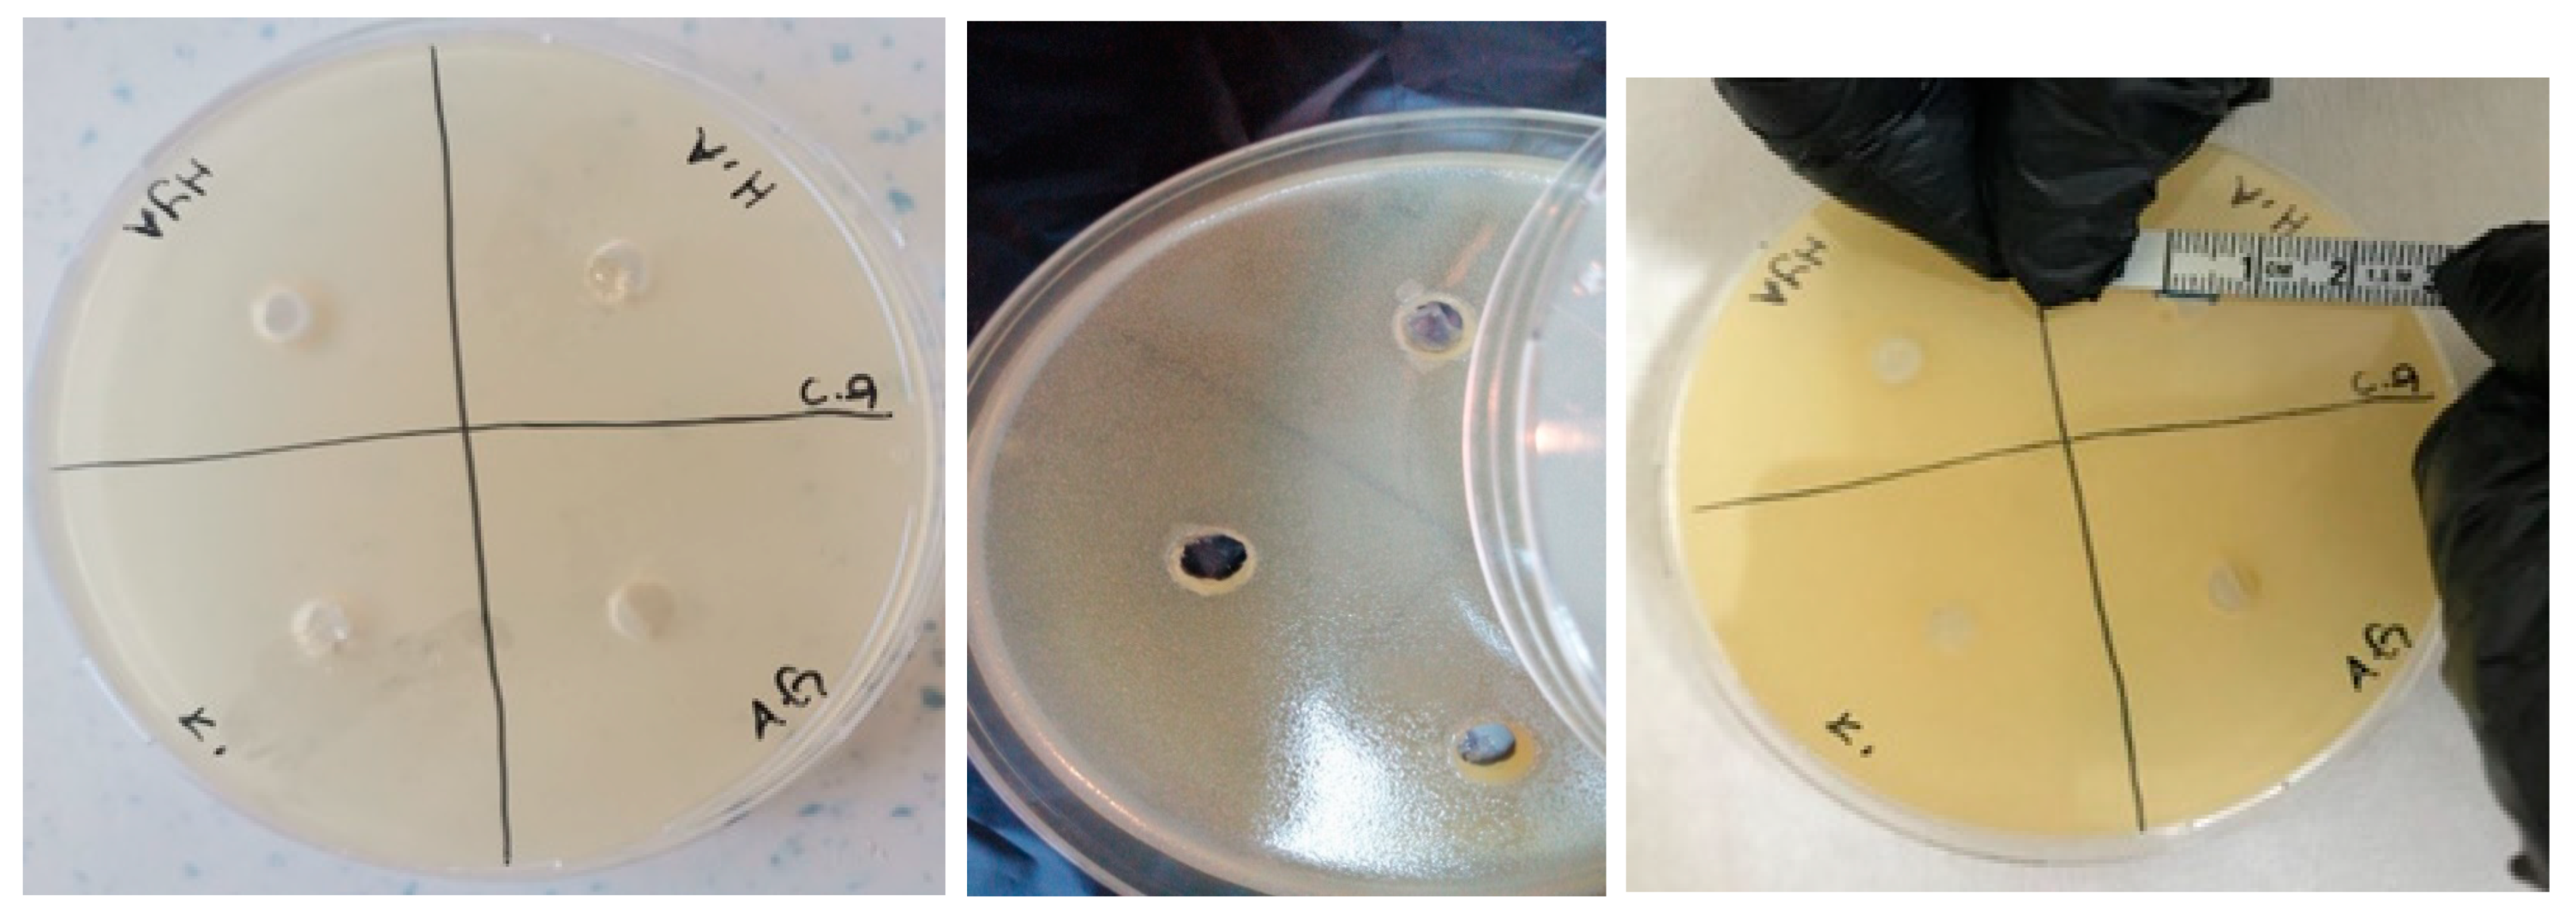
Polymers 16 01675 g013

Improving Antimicrobial Properties of GelMA Biocomposite Hydrogels for Regenerative Endodontic Treatment
Abstract
1. Introduction
2. Materials and Methods
2.1. GelMA Synthesis
2.2. Determination of the Degree of Substitution of GelMA
2.3. Injectable GelMA Biocomposite Hydrogel Synthesis
2.4. GelMA and GelMA Hydrogel Characterization
2.5. AgNP Synthesis (Green Synthesis)
2.6. Cell Culture and Cell Viability Assays
2.7. Antimicrobial Activities of GelMA Hydrogels
2.8. Statistical Analysis
3. Results
3.1. GelMA Characterization
Determination of the Degree of Substitution
3.2. Injectable GelMA Hydrogels and GelMA Biocomposite Hydrogels Synthesis
3.3. GelMA and GelMA Hydrogel Characterization
3.3.1. FTIR Characterization of GelMA
3.3.2. H-NMR Characterization of GelMA
3.3.3. SEM Characterization of GelMA Hydrogel
3.3.4. Swelling Behavior of GelMA Hydrogels
3.3.5. Biodegradation Behavior of GelMA Hydrogel
3.4. AgNP Synthesis (Green Synthesis)
3.5. The Effects of Hydrogels on Cell Viability
3.6. Antimicrobial Activities of GelMA Hydrogels
4. Discussion
5. Conclusions
Author Contributions
Funding
Institutional Review Board Statement
Data Availability Statement
Acknowledgments
Conflicts of Interest
References
- Freed, L.E.; Vunjak-Novakovic, G.; Biron, R.J.; Eagles, D.B.; Lesnoy, D.C.; Barlow, S.K.; Langer, R. Biodegradable Polymer Scaffolds for Tissue Engineering. Bio/technology 1994, 12, 689–693. [Google Scholar] [CrossRef]
- Murray, P.E.; Garcia-Godoy, F.; Hargreaves, K.M. Regenerative endodontics: A review of current status and a call for action. J. Endod. 2007, 4, 377–390. [Google Scholar] [CrossRef]
- Chang, B.; Ahuja, N.; Ma, C.; Liu, X. Injectable scaffolds: Preparation and application in dental and craniofacial regeneration. Mat. Sci. Eng. R. 2017, 111, 1–26. [Google Scholar] [CrossRef]
- Fan, C.; Wang, D.-A. Macroporous hydrogel scaffolds for three-dimensional cell culture and tissue engineering. Tissue Eng. Part B Rev. 2017, 5, 451–461. [Google Scholar] [CrossRef] [PubMed]
- Yuan, Z.; Nie, H.; Wang, S.; Lee, C.H.; Li, A.; Fu, S.Y.; Zhou, H.; Chen, L.; Mao, J.J. Biomaterial selection for tooth regeneration. Tissue Eng. Part B Rev. 2011, 5, 373–388. [Google Scholar] [CrossRef] [PubMed]
- Temenoff, J.S.; Mikos, A.G. Injectable biodegradable materials for orthopedic tissue engineering. Biomaterials 2000, 23, 2405–2412. [Google Scholar] [CrossRef]
- Fouad, A.F.; Nosrat, A. Pulp regeneration in previously infected root canal space. Endod. Top. 2013, 1, 24–37. [Google Scholar] [CrossRef]
- Diogenes, A.; Henry, M.A.; Teixeira, F.B.; Hargreaves, K.M. An update on clinical regenerative endodontics. Endod. Top. 2013, 1, 2–23. [Google Scholar] [CrossRef]
- Ricucci, D.; Siqueira, J.F., Jr. Biofilms and apical periodontitis: Study of prevalence and association with clinical and histopathologic findings. J. Endod. 2010, 8, 1277–1288. [Google Scholar] [CrossRef]
- Kim, S.G. Infection and pulp regeneration. Dent. J. 2016, 4, 4. [Google Scholar] [CrossRef]
- Ribeiro, J.S.; Münchow, E.A.; Bordini, E.A.F.; da Rosa, W.L.d.O.; Bottino, M.C. Antimicrobial therapeutics in regenerative endodontics: A scoping review. J. Endod. 2020, 9, S115–S127. [Google Scholar] [CrossRef] [PubMed]
- Berkhoff, J.A.; Chen, P.B.; Teixeira, F.B.; Diogenes, A. Evaluation of triple antibiotic paste removal by different irrigation procedures. J. Endod. 2014, 8, 1172–1177. [Google Scholar] [CrossRef] [PubMed]
- Yassen, G.; Vail, M.; Chu, T.; Platt, J. The effect of medicaments used in endodontic regeneration on root fracture and microhardness of radicular dentine. Int. Endod. J. 2013, 7, 688–695. [Google Scholar] [CrossRef] [PubMed]
- Yassen, G.H.; Chu, T.-M.G.; Eckert, G.; Platt, J.A. Effect of medicaments used in endodontic regeneration technique on the chemical structure of human immature radicular dentin: An in vitro study. J. Endod. 2013, 2, 269–273. [Google Scholar] [CrossRef] [PubMed]
- Krithikadatta, J.; Indira, R.; Dorothykalyani, A.L. Disinfection of dentinal tubules with 2% chlorhexidine, 2% metronidazole, bioactive glass when compared with calcium hydroxide as intracanal medicaments. J. Endod. 2007, 12, 1473–1476. [Google Scholar] [CrossRef]
- Althumairy, R.I.; Teixeira, F.B.; Diogenes, A. Effect of dentin conditioning with intracanal medicaments on survival of stem cells of apical papilla. J. Endod. 2014, 4, 521–525. [Google Scholar] [CrossRef] [PubMed]
- Kim, S.; Malek, M.; Sigurdsson, A.; Lin, L.; Kahler, B. Regenerative endodontics: A comprehensive review. Int. Endod. J. 2018, 12, 1367–1388. [Google Scholar] [CrossRef]
- Gasperini, L.; Mano, J.F.; Reis, R.L. Natural polymers for the microencapsulation of cells. J. R. Soc. Interface 2014, 100, 20140817. [Google Scholar] [CrossRef] [PubMed]
- Pierce, B.F.; Pittermann, E.; Ma, N.; Gebauer, T.; Neffe, A.T.; Hölscher, M.; Jung, F.; Lendlein, A. Viability of Human Mesenchymal Stem Cells Seeded on Crosslinked Entropy-Elastic Gelatin-Based Hydrogels. Macromol. Biosci. 2012, 3, 312–321. [Google Scholar] [CrossRef]
- Qu, T.; Liu, X. Nano-structured gelatin/bioactive glass hybrid scaffolds for the enhancement of odontogenic differentiation of human dental pulp stem cells. J. Mat. Chem. B 2013, 37, 4764–4772. [Google Scholar] [CrossRef]
- Van Den Bulcke, A.I.; Bogdanov, B.; De Rooze, N.; Schacht, E.H.; Cornelissen, M.; Berghmans, H. Structural and rheological properties of methacrylamide modified gelatin hydrogels. Biomacromolecules 2000, 1, 31–38. [Google Scholar] [CrossRef] [PubMed]
- Yue, K.; Trujillo-de Santiago, G.; Alvarez, M.M.; Tamayol, A.; Annabi, N.; Khademhosseini, A. Synthesis, properties, and biomedical applications of gelatin methacryloyl (GelMA) hydrogels. Biomaterials 2015, 73, 254–271. [Google Scholar] [CrossRef] [PubMed]
- Xiao, S.; Zhao, T.; Wang, J.; Wang, C.; Du, J.; Ying, L.; Lin, J.; Zhang, C.; Hu, W.; Wang, L. Gelatin methacrylate (GelMA)-based hydrogels for cell transplantation: An effective strategy for tissue engineering. Stem Cell Rev. Rep. 2019, 15, 664–679. [Google Scholar] [CrossRef] [PubMed]
- Rai, M.K.; Deshmukh, S.; Ingle, A.; Gade, A. Silver nanoparticles: The powerful nanoweapon against multidrug-resistant bacteria. J. Appl. Microbiol. 2012, 5, 841–852. [Google Scholar] [CrossRef] [PubMed]
- Lara, H.H.; Ayala-Núñez, N.V.; Ixtepan Turrent, L.d.C.; Rodríguez Padilla, C. Bactericidal effect of silver nanoparticles against multidrug-resistant bacteria. World J. Microbiol. Biotechnol. Lett. 2010, 26, 615–621. [Google Scholar] [CrossRef]
- Bhushan, J.; Maini, C. Nanoparticles: A promising novel adjunct for dentistry. Indian J. Dent. Sci. 2019, 3, 167–173. [Google Scholar] [CrossRef]
- Garg, H.G.; Hales, C.A. Chemistry and Biology of Hyaluronan; Elsevier: Amsterdam, The Netherlands, 2004. [Google Scholar]
- Sharifi, S.; Zununi Vahed, S.; Ahmadian, E.; Maleki Dizaj, S.; Abedi, A.; Hosseiniyan Khatibi, S.M.; Samiei, M. Stem cell therapy: Curcumin does the trick. Phytother. Res. 2019, 11, 2927–2937. [Google Scholar] [CrossRef] [PubMed]
- Jiang, L.; Li, Y.; Xiong, C.; Su, S.; Ding, H. Preparation and properties of bamboo fiber/nano-hydroxyapatite/poly (lactic-co-glycolic) composite scaffold for bone tissue engineering. ACS Appl. Mat. Interfaces 2017, 5, 4890–4897. [Google Scholar] [CrossRef] [PubMed]
- Ragab, H.; Ibrahim, F.; Abdallah, F.; Al-Ghamdi, A.A.; El-Tantawy, F.; Radwan, N.; Yakuphanoglu, F. Synthesis and in vitro antibacterial properties of hydroxyapatite nanoparticles. IOSR J. Pharm. Biol. Sci. 2014, 9, 77–85. [Google Scholar] [CrossRef]
- Uchida, K.; Otake, K.; Inoue, M.; Koike, Y.; Matsushita, K.; Tanaka, K.; Inoue, Y.; Mohri, Y.; Kusunoki, M. Bacteriostatic effects of hyaluronan-based bioresorbable membrane. Surg. Sci. 2011, 2, 431. [Google Scholar] [CrossRef]
- Zamboni, F.; Wong, C.K.; Collins, M.N. Hyaluronic acid association with bacterial, fungal and viral infections: Can hyaluronic acid be used as an antimicrobial polymer for biomedical and pharmaceutical applications? Bioact. Mater. 2023, 19, 458–473. [Google Scholar] [CrossRef]
- Guzińska, K.; Kaźmierczak, D.; Dymel, M.; Pabjańczyk-Wlazło, E.; Boguń, M. Anti-bacterial materials based on hyaluronic acid: Selection of research methodology and analysis of their anti-bacterial properties. Mat. Sci. Eng. C 2018, 93, 800–808. [Google Scholar] [CrossRef]
- Wang, J.; Wang, X.; Liang, Z.; Lan, W.; Wei, Y.; Hu, Y.; Wang, L.; Lei, Q.; Huang, D. Injectable antibacterial Ag-HA/GelMA hydrogel for bone tissue engineering. Front. Bioeng. 2023, 11, 1219460. [Google Scholar] [CrossRef]
- Velasco-Rodriguez, B.; Diaz-Vidal, T.; Rosales-Rivera, L.C.; García-González, C.A.; Alvarez-Lorenzo, C.; Al-Modlej, A.; Domínguez-Arca, V.; Prieto, G.; Barbosa, S.; Soltero Martínez, J.F.A. Hybrid methacrylated gelatin and hyaluronic acid hydrogel scaffolds. Preparation and systematic characterization for prospective tissue engineering applications. Int. J. Mol. Sci. 2021, 13, 6758. [Google Scholar] [CrossRef] [PubMed]
- Li, L.; Lu, C.; Wang, L.; Chen, M.; White, J.; Hao, X.; McLean, K.M.; Chen, H.; Hughes, T.C. Gelatin-based photocurable hydrogels for corneal wound repair. ACS Appl. Mater. Interfaces 2018, 16, 13283–13292. [Google Scholar] [CrossRef]
- Shirahama, H.; Lee, B.H.; Tan, L.P.; Cho, N.-J. Precise tuning of facile one-pot gelatin methacryloyl (GelMA) synthesis. Sci. Rep. 2016, 6, 31036. [Google Scholar] [CrossRef]
- Levett, P.A.; Melchels, F.P.; Schrobback, K.; Hutmacher, D.W.; Malda, J.; Klein, T.J. A biomimetic extracellular matrix for cartilage tissue engineering centered on photocurable gelatin, hyaluronic acid and chondroitin sulfate. Acta Biomater. 2014, 1, 214–223. [Google Scholar] [CrossRef] [PubMed]
- Vitale, M.; Ligorio, C.; McAvan, B.; Hodson, N.W.; Allan, C.; Richardson, S.M.; Hoyland, J.A.; Bella, J. Hydroxyapatite-decorated Fmoc-hydrogel as a bone-mimicking substrate for osteoclast differentiation and culture. Acta Biomater. 2022, 138, 144–154. [Google Scholar] [CrossRef]
- Bilušić, T.; Šola, I.; Rusak, G.; Poljuha, D.; Čikeš Čulić, V. Antiproliferative and pro-apoptotic activities of wild asparagus (Asparagus acutifolius L.), black bryony (Tamus communis L.) and butcher’s broom (Ruscus aculeatus L.) aqueous extracts against T24 and A549 cancer cell lines. J. Food Biochem. 2019, 4, e12781. [Google Scholar] [CrossRef] [PubMed]
- Mosmann, T. Rapid colorimetric assay for cellular growth and survival: Application to proliferation and cytotoxicity assays. J. Immunol. Methods 1983, 1–2, 55–63. [Google Scholar] [CrossRef]
- Onem, E.; Soyocak, A.; Muhammed, M.T.; Ak, A.J. In vitro and in silico assessment of the potential of niaouli essential oil as a quorum sensing inhibitor of biofilm formation and its effects on fibroblast cell viability. Braz. Arch. Biol. Techn. 2021, 64, e21200782. [Google Scholar] [CrossRef]
- Manandhar, S.; Luitel, S.; Dahal, R.K. In vitro antimicrobial activity of some medicinal plants against human pathogenic bacteria. J. Trop.Med. 2019, 2019, 1895340. [Google Scholar] [CrossRef] [PubMed]
- Panpaliya, N.P.; Dahake, P.T.; Kale, Y.J.; Dadpe, M.V.; Kendre, S.B.; Siddiqi, A.G.; Maggavi, U.R. In vitro evaluation of antimicrobial property of silver nanoparticles and chlorhexidine against five different oral pathogenic bacteria. Saudi Dent. J. 2019, 1, 76–83. [Google Scholar] [CrossRef] [PubMed]
- Arslan, P.; Tayyar, A.E. Tekstil Alanında Kullanılan Antimikrobiyal Maddeler, Çalışma Mekanizmaları, Uygulamaları ve Antimikrobiyal Etkinlik Değerlendirme Yöntemleri. Düzce Univ. J. Sci. Technol. 2016, 4, 935–966. [Google Scholar]
- Ajay Sharma, L.; Sharma, A.; Dias, G.J. Advances in regeneration of dental pulp–a literature review. J. Investig. Clin. Dent. 2015, 2, 85–98. [Google Scholar] [CrossRef] [PubMed]
- Bilgili, B.; Karademir, F.; Bozacı, E.; Özdoğan, E.; Ayhan, H.; Ayhan, F. Liquidambar orientalis mill. leaf aqueous extract for the synthesis of silver nanoparticles and immobilization on textile fabrics for biomedical applications. Text. Appar. 2016, 4, 421–429. [Google Scholar]
- Almutairi, W.; Yassen, G.H.; Aminoshariae, A.; Williams, K.A.; Mickel, A. Regenerative endodontics: A systematic analysis of the failed cases. J. Endod. 2019, 5, 567–577. [Google Scholar] [CrossRef]
- Diogenes, A.; Hargreaves, K.M. Microbial modulation of stem cells and future directions in regenerative endodontics. J. Endod. 2017, 9, S95–S101. [Google Scholar] [CrossRef]
- Windley, I.I.I.W.; Teixeira, F.; Levin, L.; Sigurdsson, A.; Trope, M. Disinfection of immature teeth with a triple antibiotic paste. J. Endod. 2005, 6, 439–443. [Google Scholar] [CrossRef]
- Ruparel, N.B.; Teixeira, F.B.; Ferraz, C.C.; Diogenes, A. Direct effect of intracanal medicaments on survival of stem cells of the apical papilla. J. Endod. 2012, 10, 1372–1375. [Google Scholar] [CrossRef]
- Aksel, H.; Mahjour, F.; Bosaid, F.; Calamak, S.; Azim, A.A. Antimicrobial activity and biocompatibility of antibiotic-loaded chitosan hydrogels as a potential scaffold in regenerative endodontic treatment. J. Endod. 2020, 12, 1867–1875. [Google Scholar] [CrossRef]
- Piva, E.; Silva, A.F.; Nör, J.E. Functionalized scaffolds to control dental pulp stem cell fate. J. Endod. 2014, 4, S33–S40. [Google Scholar] [CrossRef] [PubMed]
- Vargas-Alfredo, N.; Munar-Bestard, M.; Ramis, J.M.; Monjo, M. Synthesis and Modification of Gelatin Methacryloyl (GelMA) with Antibacterial Quaternary Groups and Its Potential for Periodontal Applications. Gels 2022, 8, 630. [Google Scholar] [CrossRef]
- Franci, G.; Falanga, A.; Galdiero, S.; Palomba, L.; Rai, M.; Morelli, G.; Galdiero, M. Silver nanoparticles as potential antibacterial agents. Molecules 2015, 5, 8856–8874. [Google Scholar] [CrossRef] [PubMed]
- Brzóska, K.; Męczyńska-Wielgosz, S.; Stępkowski, T.M.; Kruszewski, M. Adaptation of HepG2 cells to silver nanoparticles-induced stress is based on the pro-proliferative and anti-apoptotic changes in gene expression. Mutagenesis 2015, 3, 431–439. [Google Scholar] [CrossRef] [PubMed]
- Fischer, M.; Vahdatzadeh, M.; Konradi, R.; Friedrichs, J.; Maitz, M.F.; Freudenberg, U.; Werner, C. Multilayer hydrogel coatings to combine hemocompatibility and antimicrobial activity. Biomaterials 2015, 56, 198–205. [Google Scholar] [CrossRef] [PubMed]
- Jeong, S.H.; Hwang, Y.H.; Yi, S.C. Antibacterial properties of padded PP/PE nonwovens incorporating nano-sized silver colloids. J. Mat. Sci. 2005, 40, 5413–5418. [Google Scholar] [CrossRef]
- McShan, D.; Ray, P.C.; Yu, H.J.J. Molecular toxicity mechanism of nanosilver. J. Food Drug Anal. 2014, 1, 116–127. [Google Scholar] [CrossRef] [PubMed]
- Silva-Holguín, P.N.; Reyes-López, S.Y. Synthesis of hydroxyapatite-Ag composite as antimicrobial agent. Dose-Response 2020, 3, 1559325820951342. [Google Scholar] [CrossRef]
- Romanò, C.; Vecchi, E.D.; Bortolin, M.; Morelli, I.; Drago, L. Hyaluronic acid and its composites as a local antimicrobial/antiadhesive barrier. Bone Jt. J. 2017, 1, 63–72. [Google Scholar] [CrossRef]
- Pirnazar, P.; Wolinsky, L.; Nachnani, S.; Haake, S.; Pilloni, A.; Bernard, G.W. Bacteriostatic effects of hyaluronic acid. J. Periodontol. 1999, 4, 370–374. [Google Scholar] [CrossRef] [PubMed]
- Cross, E.R.; Coulter, S.M.; Pentlavalli, S.; Laverty, G. Unravelling the antimicrobial activity of peptide hydrogel systems: Current and future perspectives. Soft Matter 2021, 35, 8001–8021. [Google Scholar] [CrossRef] [PubMed]
- Pelgrift, R.Y.; Friedman, A.J. Nanotechnology as a therapeutic tool to combat microbial resistance. Adv. Drug Deliv. Rev. 2013, 13–14, 1803–1815. [Google Scholar] [CrossRef] [PubMed]
- Athirasala, A.; Lins, F.; Tahayeri, A.; Hinds, M.; Smith, A.J.; Sedgley, C.; Ferracane, J.; Bertassoni, L.E. A novel strategy to engineer pre-vascularized full-length dental pulp-like tissue constructs. Sci. Rep. 2017, 7, 3323. [Google Scholar] [CrossRef] [PubMed]
- Khayat, A.; Monteiro, N.; Smith, E.; Pagni, S.; Zhang, W.; Khademhosseini, A.; Yelick, P. GelMA-encapsulated hDPSCs and HUVECs for dental pulp regeneration. J. Dent. Res. 2017, 2, 192–199. [Google Scholar] [CrossRef] [PubMed]
- Ha, M.; Athirasala, A.; Tahayeri, A.; Menezes, P.P.; Bertassoni, L.E. Micropatterned hydrogels and cell alignment enhance the odontogenic potential of stem cells from apical papilla in-vitro. Dent. Mat. 2020, 1, 88–96. [Google Scholar] [CrossRef]
- Jang, J.-H.; Moon, J.-H.; Kim, S.G.; Kim, S.-Y. Pulp regeneration with hemostatic matrices as a scaffold in an immature tooth minipig model. Sci. Rep. 2020, 1, 12536. [Google Scholar] [CrossRef]

| Inhibition Zone Diameters (mm) | ||||||||
|---|---|---|---|---|---|---|---|---|
| GelMA | GelMA/AgNP | GelMA/HA | GelMA/HYA | |||||
| Microorganism Type | 24 h * | 48 h * | 24 h * | 48 h * | 24 h * | 48 h * | 24 h * | 48 h * |
| Enterococcus faecalis ATCC 29212 | Bottom of sample ** 2 ± 0.00 c | Bottom of sample ** 2 ± 0.00 c | Bottom of sample ** 4 ± 0.00 a,b | Bottom of sample ** 4 ± 0.00 a,b | Bottom of sample ** 3 ± 0.00 b,c | Bottom of sample ** 3 ± 0.00 b,c | Bottom of sample ** 5.5 ± 0.35 a | Bottom of sample ** 5.5 ± 0.35 a |
| Staphylococcus aureus ATCC 6538/P | Bottom of sample ** 3.75 ± 0.18 b | Bottom of sample ** 3.75 ± 0.18 b | 6 + 1.5 (Well diameter + zone) *** ±0.35 a | 6 + 1.5 (Well diameter + zone) *** ±0.35 a | Bottom of sample ** 5.5 ± 0.35 a,b | Bottom of sample ** 5.5 ± 0.35 a,b | Bottom of sample ** 5 ± 0.00 b | Bottom of sample ** 5 ± 0.00 b |
| Escherichia coli ATCC 35218 | Bottom of sample ** 3 ± 0.00 d | Bottom of sample ** 3 ± 0.00 d | Bottom of sample ** 6 ± 0.00 a | Bottom of sample ** 6 ± 0.00 a | Bottom of sample ** 5.25 ± 0.18 a,b | Bottom of sample ** 5 ± 0.00 b,c | Bottom of sample ** 4.25 ± 0.18 c | Bottom of sample ** 4.25 ± 0.18 c |
| Pseudomonas aeruginosa ATCC 27853 | Bottom of sample ** 2.5 ± 0.35 b | Bottom of sample ** 2.5 ± 0.35 b | 6 + 1 (Well diameter + zone) *** ±0.00 a | 6 + 1 (Well diameter + zone) *** ±0.00 a | 6+0.25 (Well diameter + zone) *** ±0.18 a | 6 + 0.25 (Well diameter + zone) *** ±0.18 a | Bottom of sample ** 3.5 ± 0.35 b | Bottom of sample ** 3.5 ± 0.35 b |
| Candida albicans ATCC 10239 | Bottom of sample ** 1.75 ± 0.18 b | Bottom of sample ** 1.75 ± 0.18 b | Bottom of sample ** 2.5 ± 0.35 ±0.00 b | Bottom of sample ** 2.75 ± 0.18 b | 6 + 0.75 (Well diameter + zone) *** ±0.18 a | 6 + 0.75 (Well diameter + zone) *** ±0.18 a | Bottom of sample ** 4 ± 0.70 a,b | Bottom of sample ** 4 ± 0.70 a,b |
Disclaimer/Publisher’s Note: The statements, opinions and data contained in all publications are solely those of the individual author(s) and contributor(s) and not of MDPI and/or the editor(s). MDPI and/or the editor(s) disclaim responsibility for any injury to people or property resulting from any ideas, methods, instructions or products referred to in the content. |
© 2024 by the authors. Licensee MDPI, Basel, Switzerland. This article is an open access article distributed under the terms and conditions of the Creative Commons Attribution (CC BY) license (https://creativecommons.org/licenses/by/4.0/).
Share and Cite
Dorterler, O.C.; Akgun, B.; Alper, M.; Ayhan, F. Improving Antimicrobial Properties of GelMA Biocomposite Hydrogels for Regenerative Endodontic Treatment. Polymers 2024, 16, 1675. https://doi.org/10.3390/polym16121675
Dorterler OC, Akgun B, Alper M, Ayhan F. Improving Antimicrobial Properties of GelMA Biocomposite Hydrogels for Regenerative Endodontic Treatment. Polymers. 2024; 16(12):1675. https://doi.org/10.3390/polym16121675
Chicago/Turabian StyleDorterler, Ozgul C., Berre Akgun, Mehlika Alper, and Fatma Ayhan. 2024. "Improving Antimicrobial Properties of GelMA Biocomposite Hydrogels for Regenerative Endodontic Treatment" Polymers 16, no. 12: 1675. https://doi.org/10.3390/polym16121675
APA StyleDorterler, O. C., Akgun, B., Alper, M., & Ayhan, F. (2024). Improving Antimicrobial Properties of GelMA Biocomposite Hydrogels for Regenerative Endodontic Treatment. Polymers, 16(12), 1675. https://doi.org/10.3390/polym16121675

